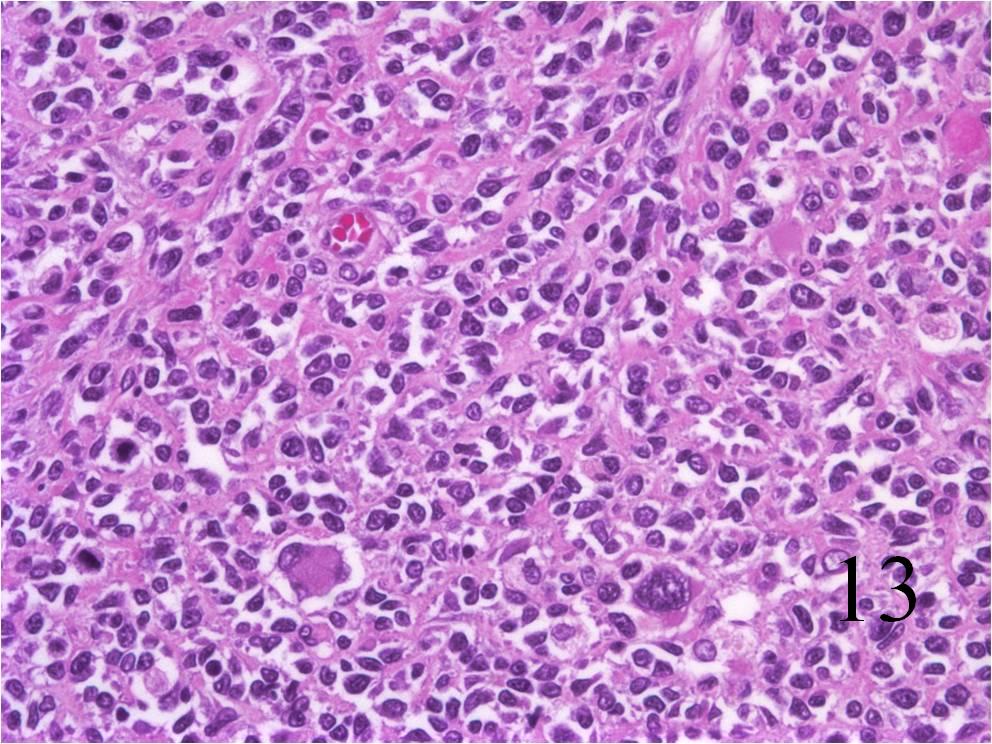

GENERAL INFORMATION
Rhabdomyosarcoma is a malignant soft tissue tumor (sarcoma) originating from striated skeletal muscle. Although rare, it is one of the more common solid cancerous tumors (sarcoma) affecting children. This entity occurs with same frequency in the genitourinary system, head and neck, retroperitoneum/pelvis, and extremity (lower extremity>upper extremity). Patients usually complaint of a painless mass although it may be painful. Rhabdomyosarcoma have no specific radiological features and 24% of cases invade adjacent bone.
CLINICAL DATA
- Most common malignant soft tissue tumor in children
- Almost 10% of all childhood neoplasms
- Presents some times as painful mass
- 3 major types:
- Embryonal:
- Malignant small blue cells
- Skeletal muscle differentiation
- 4 subtypes:
- Embryonal
- Botryoid
- Spindle cell
- Anaplatic
- Embryonal:
- Alveolar:
- High-grade
- Solid and alveolar growth of cells
- Some skeletal muscle differentiation
- Pleomorphic:
- High-grade
- Large, bizarre, round and spindle-shaped cells
- Some skeletal muscle differentiation.
Differential diagnosis
- Ewing sarcoma and primitive neuroectodermal tumors
- Non-hodgkin lymphoma
- Extraskeletal myxoid chondrosarcoma
- Epitheloid fibrosarcoma
- Angiosarcoma
- Synovial sarcoma
CLINICAL PRESENTATION
Signs/Symptoms
- Soft tissue mass that may or not be painful.
- Symptoms vary depending of the location
Prevalence
- Sight preference for Male>Female
- Embryonal: 70-75% of the cases
- Alveolar: 20-25%
- Pleomorphic: <5%
- Peak age of presentation is during first decade of life, but some cases can occur between second and third decades.
- Extremely rare in adults
Sites
- EMBRYONAL—->Head, neck, extremities, genitourinary tract, gastrointestinal tract, perinal region
- ALVEOLAR——->Usually in extremities, but also can affect head, neck, trunk, pelvis, retroperitoneum.
- PLEOMORPHIC->Usually deep soft tissue of lower extremity. Chest wall, upper extremity, pelvis, retroperitoneum
RADIOGRAPHIC PRESENTATION
Plain x-ray
- No specific radiological features (Fig. 1)
- 24% of the cases invade adjacent bone
- No mineralization/calcification.
CT
- Shows a heterogeneous mass sometimes involving adjacent bone
- After contrast, the mass enhances (Fig. 2, Fig. 3)
- Hard to identify necrosis, hemorrhagic or calcification.
MRI
- Heterogeneous mass (does not follow signal of skeletal muscle)
- Isointense to skeletal muscle on T1 (Fig. 4, Fig. 5, Fig. 7, Fig. 8)
- Hyperintense signal on T2, sometimes low to intermediate signal on T2 if there is extensive fibrous tissue within the tumor (Fig. 6, Fig. 9).
- Prominent vascularity
- Deep enhancement with gadolinium
- Possible extensive hypercellular fibrous tissue and hemosiderin seen on T2



Fig. 2-3: Coronal and axial (Fig. 3) CT of a rhabdomyosarcoma of the hand shows a well circumscribed mass isointense to muscle






Fig. 4-9: MRI of a rhabdomyosarcoma of the hand. The MRI is nonspecific and shows a heterogeneous mass particularly on postgadolinium images T1 W images (Fig. 8) and T2 W images (Fig. 9).
PATHOLOGY
Gross
- Fleshy, solid and well circumscribed with a pseudocapsule (Fig. 10)
- Hemorrhage and necrosis evident
Microscopic
- Embryonal:
- Small round blue cells (Fig. 12-15)
- Round, oval, polygonal cells
- Fibrotic/myxoid stroma
- Rhabdomyoblast: well differentiated will have cross striations
- Alveolar:
- Tumor cells grow in nest or clusters
- Identify rhabdomyoblasts with cross striations
- Pleomorphic:
- Essentially identical to pleomorphic MFH
- Admixture of spindle-shaped, pleomorphic polygonal, round cells
- Arranged in fascicular, storiform, and patternless pattern
- Nuclei is large, oval-round, and multiple.
Immunohistochemistry
- Vimentin positive; Keratin negative
- Actin variable; perhaps minor scant staining
- S-100 negative
Genetic Studies
- Not reliable for Embryonal type
- Alveolar:
- t(2:13) PAX3/FKHR
- t(1;13) PAX7/FKHR

PROGNOSIS
Biological Behavior
- High metastatic rate to lung, lymph node, bone, brain, and liver
- Without chemotherapy the 5 year survival is less than 20% but with chemo it is over 65%
- Embryonal: survival, 70% DFS at 5 year; Lower recurrence rates compared to other subtypes.
- Alveolar: Worse prognosis than embryonal 56% at 3 years; Metastatic and recurrent rates are twice in comparison to embryonal
- Pleomorphic: worse prognosis of all of them; patients usually die within 1 year; high metastatic and recurrence rates.
TREATMENT
- Surgery: wide resection, chemotherapy, and possible radiation (Fig. 16-19)



Fig. 16-18: Intraoperative photograph shows a big rhabdomyosarcoma in the left calf. Photograph of a radical resection (Fig. 17) of the rhabdomyosarcoma to the calf. After the resection of the tumor (Fig. 18), multiple rotational flaps are performed to fill the dead space,
